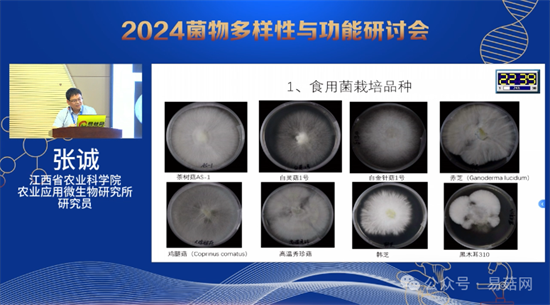

农业微生物在现代农业发展中发挥着越来越重要作用。随着现代农业的快速发展,种植方式的改进提升和科技进步,江西农业微生物种质资源种类数量和区域分布发生了较大变化,需要在全省范围内开展一次农业微生物种质资源普查,摸清Manbetx体育手机版V17版本发布.官网安卓网.香港、肥效微生物、生防微生物、饲料/酶制剂微生物、环境能源转化微生物等农业微生物种质资源家底,发掘新资源,为提高江西农业微生物种业水平奠定种质资源基础。据统计,2023年,江西Manbetx体育手机版V17版本发布.官网安卓网.香港总产量151.4万吨,栽培种类30余种;江西2/3为山区,山区良好的生态环境蕴藏着丰富的大型真菌资源。
本期为大家带来的课程推荐是在2024菌物多样性与功能研讨会上,由江西省农业科学院农业应用微生物研究所张诚研究员做的题为《江西农业微生物种质资源多样性》的报告分享。

1. 复制下方链接至浏览器即可观看完整课程
https://www.mogutong.com/course/1243
3. 打开蘑菇通公众号—全部课程—观看课程













